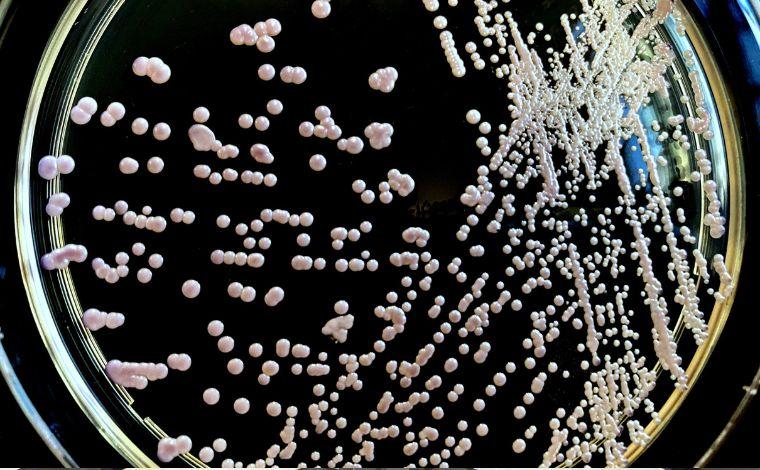

O número de pacientes infectados pelo superfungo Candida auris em Belo Horizonte subiu para quatro, segundo informou a Secretaria de Estado de Saúde de Minas Gerais (SES-MG) nesta quarta-feira (16). Dois dos pacientes já receberam alta, enquanto outros dois seguem internados no Hospital João XXIII, localizado na região Leste da capital.
Além desses casos confirmados, outros 24 pacientes que tiveram contato com os infectados estão sendo monitorados pelas autoridades de saúde. A investigação dos casos suspeitos está sendo conduzida pelo Laboratório Central de Saúde Pública (Lacen), da Fundação Ezequiel Dias (Funed), em parceria com a Secretaria Municipal de Saúde (SMSA).
Até o momento, 39 pessoas foram testadas para o fungo. Entre elas, dois pacientes testaram negativo, mas permanecem internados, enquanto nove tiveram a infecção descartada e já receberam alta.
Preocupação com a Transmissibilidade
Em nota, a SES-MG destacou a alta transmissibilidade do Candida auris e sua capacidade de colonizar rapidamente a pele dos pacientes e os ambientes ao seu redor. Por isso, medidas de isolamento são cruciais para evitar o contágio. Os leitos dos pacientes infectados estão mantidos isolados, e protocolos rigorosos de segurança sanitária estão sendo seguidos no Hospital João XXIII. Essas medidas incluem higienização constante das mãos, uso de equipamentos de proteção, como luvas e aventais, e monitoramento contínuo de novos casos.
Desde 2021, quando o primeiro caso do fungo foi identificado no Brasil, a SES-MG vem acompanhando de perto os casos suspeitos. Até o momento, 129 casos já foram descartados no estado.
Origem do Primeiro Caso em Minas Gerais
De acordo com o secretário de Estado de Saúde de Minas Gerais, Fábio Baccheretti, o primeiro caso de infecção pelo Candida auris no estado foi registrado em um paciente que havia viajado para a Colômbia, país que enfrentou um surto do fungo em 2016. A primeira notificação em Minas foi confirmada em setembro, e o paciente infectado recebeu alta no último dia 26, após internação no Hospital João XXIII.
"Esse fungo provavelmente veio de um paciente que esteve na Colômbia, onde ele já é comum em hospitais de lá. Por isso a secretaria estadual de Saúde, junto com o João XXIII, pela Fhemig, está fazendo todo o controle epidemiológico destes casos", garante Baccheretti.
O Que é o Candida auris?
O Candida auris é um fungo emergente, identificado pela primeira vez em 2009 no Japão, e que se tornou uma grave ameaça à saúde global. No Brasil, o primeiro caso foi registrado em 2020, em Salvador. A grande preocupação com esse fungo é sua resistência a medicamentos tradicionais usados para tratar infecções fúngicas. Estima-se que até 90% das cepas de Candida auris sejam resistentes ao fluconazol, anfotericina B e equinocandinas, dificultando o tratamento.
Se o fungo atingir a corrente sanguínea, ele pode se espalhar para outros órgãos, causando candidíase invasiva, uma forma grave e generalizada da infecção. A taxa de mortalidade para essa condição varia de 29% a 53%, sendo especialmente perigosa para pacientes imunodeprimidos ou com comorbidades.
As autoridades de saúde continuam monitorando os casos e reforçando medidas preventivas para controlar a disseminação desse superfungo em Belo Horizonte.
Da Redação
Sete Lagoas Notícias
FIQUE BEM INFORMADO, SIGA O SETE LAGOAS NOTÍCIAS NAS REDES SOCIAIS:
Twitter - X
https://twitter.com/7lagoasnoticias
Instagram:
https://www.instagram.com/setelagoasnoticias
Facebook: